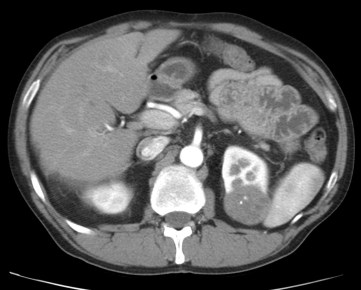
Lesión hipoatenuada en fase corticomedular con una calcificación central.

Paciente de 64 años que se realiza una ecografía por dolor abdominal en flanco izquierdo. Se observa lo siguiente:

Por tanto, nos encontramos ante una LOE sólida e hipovascular de unos 4.3 cm situada en el polo superior del riñón izquierdo, con forma de «bola» con mas del 50% de crecimiento exofítico. Con reconstrucciones y mayor análisis, se observó que no presentaba signos de invasión de espacio perirrenal o del seno ni invasión del eje vascular. La lesión contactaba con los grupos caliciales sin signos de infiltración.
Estos hallazgos son compatibles con CCR de tipo Papilar.
CARCINOMA DE CÉLULAS RENALES (CCR).
El carcinoma de células renales (CCR) es la octava neoplasia maligna más frecuente en el adulto y la más frecuente del riñón, constituye el 90% de los tumores malignos que afectan a este órgano. Es una enfermedad heterogénea, con múltiples subtipos que tienen diferentes expresiones clínicas, anatomopatológicas y citogenéticas y distintas respuestas terapéuticas.
Es más frecuente en hombres entre la 6ª y 7ª década de la vida. La incidencia del CCR está aumentando debido al uso generalizado de la ecografía abdominal y la tomografía computarizada. Hoy en día lo más habitual es detectarlo incidentalmente y es infrecuente ver la antigua triada clásica de hematuria, dolor en flanco y masa abdominal palpable, que de presentarse supone un mal pronóstico. Hoy en día, las lesiones que diagnosticamos son más pequeñas (<4cm) y de menor estadio y grado histopatológico, lo cual permite un tratamiento más conservador. Concretamente, los CCR suelen presentar forma de «bola» con crecimiento expansivo que puede producir compresión y deformación del parénquima renal adyacente
Clasificación de Subtipos:
- Células claras o Hipernefroma: Es el subtipo más frecuente (65-70%)
- Papilar (15-20%),
- Cromófobo (6-11%)
- Otros subtipos (5%): Medular, Conductos colectores, Císitco multilocular, Síndromes de cáncer renal hereditario (La enfermedad de von-Hippel-Lindau asociado al c. de células claras es el síndrome más frecuente).
TÉCNICAS DE ESTUDIO:
- Ecografía: La S es menor que la TC y RM, especialmente si las lesiones son pequenas. Es especialmente útil para establecer rápidamente la naturaleza sólida o quística del tumor sin irradiación, es accesible e independiente de la función renal. Con contraste ecográfico es muy sensible para detectar pequeñas zonas de captación.
- TC: Alta resolución espacial. Es la técnica de ELECCIÓN por su disponibilidad. Además, permite hacer estudios multifásicos rápidos con un alto grado de definición de las estructuras abdominales, con reconstrucciones multiplanares y en 3D, con muy pocos artefactos.
- RM: Alta resolución tisular. Junto con la TCMD son las técnicas más utilizadas. Es menos disponible y más susceptible a los artefactos. Sin embargo tiene ventajas porque no necesita contraste yodado (útil para alérgicos, pacientes con mala función renal), no irradia, permite un estudio multifásico y multiplanar, detecta mejor la grasa intratumoral y la hemorragia intraquística, caracteriza mejor los quistes complejos, y es excelente para detectar y definir la extensión de la trombosis tumoral en las venas renales y la cava inferior.
- PET-TAC: La tomografía por emisión de positrones (PET)-18FDG y la PET-18 FDG/TC no están recomendadas sistemáticamente, porque la eliminación del radiotrazador es renal. Sin embargo, son útiles para detectar las metástasis y se están evaluando en ensayos clínicos para valorar la respuesta a tratamientos sistémicos.
- Extensión: La radiografía de tórax es suficiente para estadificar a pacientes de bajo riesgo (tumores menores de 3 cm). La TCMD torácica se reserva para los de alto riesgo (tumores mayores de 3 cm). El estudio cerebral (TCMD/RM) y la gammagrafía ósea se harán cuando la historia clínica o la exploración física lo aconsejen.
- Punción-aspiración o biopsia de las masas renales. En los últimos años se ha replanteado su papel y se emplea más debido a que aproximadamente un 20% de las masas renales en estadio T1 son benignas, a la mejora progresiva de la seguridad y precisión de las técnicas de biopsia (falsos positivos < 1% y complicaciones sintomáticas < 2%) y al aumento de las opciones terapéuticas disponibles para tratar tumores en estadio T1. Aún así, el porcentaje de biopsias con resultados no concluyentes es es un 30% aprox. La diseminación tumoral por el trayecto de la aguja de biopsia es extremadamente infrecuente.
PROTOCOLO DE ESTUDIO:
Cuando se detecta una masa renal, lo primero es diferenciar si es un tumor o seudotumor (falso tumor):
- Estructuras anatómica (columna de Bertin hipertrófica, giba cortical).
- Proceso inflamatorio (pielonefritis focal, absceso crónico).
- Estructuras vasculares (aneurismas de arterias renales, fístula arteriovenosa).
- Secuela postraumática.
Una vez excluido el seudotumor, debe establecerse si la masa es quística o sólida y en ambos casos intentar determinar si es benigna o maligna. Aproximadamente un 15% de los CCR son quísticos, y frecuentemente tienen unas características que se solapan con los quistes complejos benignos. Para ello, usamos la clasificación de Bosniak, que relaciona la probabilidad de malignidad de una lesión con una serie de características morfológicas. Fue ideada originalmente para la TC pero es adaptable a la RM y a la ecografía con contraste. Tiene 5 categorías, con una probabilidad creciente de corresponder a una lesión maligna
La clasificación no incluye el tamaño de una lesión quística, ya que éste no es un buen predictor de malignidad; aunque la gran mayoría de los quistes renales menores de 1 cm son benignos. Bosniak 2 F: La «F» indica la necesidad de seguirlos (follow-up), ya que tienen un 5% de probabilidad de ser malignos.
La mayoría de los tumores sólidos renales en el adulto son CCR y la forma de presentación más frecuente del CCR es la de un nódulo sólido cortical en forma de «bola» que realza tras inyectar contraste y que posteriormente lava. No obstante, hasta un 20% de los nódulos renales que realzan son benignos y el tamaño per se no es un criterio útil para decidir el tratamiento. La mayor parte de las lesiones benignas diagnosticadas en las piezas quirúrgicas inicialmente valoradas como CCR son angiomiolipomas con muy poca grasa y oncocitomas. Al detectar un nódulo sólido renal lo primero es determinar si la lesión contiene grasa y así descartar un angiomiolipoma. Si no se detecta grasa con TCMD o RM (la ecografía no es sensible)lo más probable es que se trate de un CCR (células claras,papilar, cromófobo), una lesión benigna como el angiomiolipoma con muy poca grasa (5% de los angiomiolipomas) o un oncocitoma. Las lesiones sólidas benignas o malignas y sin grasa macroscópica (agotadas las técnicas radiológicas para el diagnóstico del angiomiolipoma) son indiferenciables. La calcificación puede verse en los TC sin contraste hasta en el 30% de los CCR. La calcificación periférica de una masa está más relacionada a quiste benigno, mientras que la calcificación central es más característico del CCR.
Para evaluar una masa renal mediante TCMD y RM se necesita un protocolo de estudio específico de 4 fases. Hay que destacar que un signo radiológico fundamental para valorar una lesión, es el comportamiento o cambios de realce de la lesión al realizar a las diferentes fases. Aumentos y disminuciones de realce de más de 15 UH se consideran significativos, aunque siempre deber combinar este hallazgo con el resto de características morfológicas de la lesión.
- Fase basal. Antes de inyectar contraste intravenoso, útil para detectar calcificaciones, además de ser la base para comparar posteriormente el grado de realce de una lesión en unidades Hounsfield (UH). El realce tras la administración de contraste nos permite diferenciar quistes de lesiones sólidas. La mayoría de lesiones sólidas tienen más de 20 UH, las lesiones pequeñas son homogéneas y las de mayor tamaño más heterogéneas. Podemos observar calcificaciones hasta un 30%.
- Fase corticomedular. Aproximadamente a los 35s después de inyectar contraste intravenoso. El contraste se localiza en los capilares corticales, espacios peritubulares, lámina cortical tubular y aún no se ha filtrado en los túbulos renales distales. El córtex se realza con respecto a la médula y nos permite su diferenciación. Proporciona el mejor detalle vascular (arterial y venoso), el grado de realce de la lesión y permite identificar metástasis hipervasculares. Por contra, es limitada para la valoración de pequeñas lesiones, como carcinomas pequeños hipervasculares que pueden confundirse con el realce del córtex o lesiones centrales hipoatenuadas que se localicen en la médula. Realces heterogéneos en la médula pueden ser confundidos con un tumor y ser causa de falos positivo.
- Fase nefrográfica. Aproximadamente a los 90s. Se produce a medida que el contraste pasa a las asas de Henle y llega a los túbulos colectores. Así, el parénquima renal se realza de forma homogénea (tanto corteza como médula) y es óptima para detectar y caracterizar masas renales, especialmente las pequeñas, y diferenciarla de la médula normal. Es la fase más valiosa para detectar masas renales y para caracterizar lesiones indeterminadas.
- Fase excretora. A partir de los 3 min. El realce del nefrogama va decreciendo ya que el contraste se encuentra en el sistema colector. Permite definir la relación de la lesión con el sistema colector, lo que es especialmente útil para planificar una intervención quirúrgica conservadora, y también caracterizar lesiones según su patrón de lavado, es decir, permiete diferenciar quistes de masas; por ejemplo: un quiste hiperdenso no tiene cambios de realce tras 15 minutos de lavado y en una lesión maligna el realce del tumor va disminuyendo con el paso del tiempo.

Quiste hiperdenso se define como alquel quiste que tiene un realce en TC sin contraste alrededor de 85 UH y que tras la administración de contraste no posee un cambio significativo. De este modo podemos decir que no se trata de un CCR.

Lesión en polo inferior del RI que tiene un cambios de realce significativo entre un TC sin contraste y un TC en fase nefrográfica. Diagnóstico de CCR probablemente de células claras.
Con la TCMD estudiaremos el patrón de realce de la lesión en las diferentes fases y con RM analizaremos la lesión en las diferentes secuencias realizadas. A continuación las explicaremos.
1). CCR DE CÉLULAS CLARAS:
Es la variedad más frecuente, constituye el 70% de todos los CCR. Procede de los túbulos contorneados proximales. Son heterogéneos debido a la presencia de necrosis, hemorragia y quistes. Hiperdenso en TC con contraste, Hipointenso en T1, Hiperintenso en T2. Puede contener focos microscópicos lipídicos que hacen caer la señal en la fase opuesta Eco Gradiente T1. Puede contener cambios quísticos en aproximadamente un 15% de los casos y calcificaciones en un 10-15%. La multicentricidad y bilateralidad es poco frecuente (< 5%) en los casos esporádicos. La mitad están en estadio 1 y 2, la invación capsular o de la vena renal se ve en el 45% de los tumores. Los pulmones (75%), el hígado y el hueso son los lugares más frecuentes de metástasis.


2). CCR PAPILAR:
Corresponde con el caso que presentabamos al principio del post. Hipovacular y homogéneo, con un grado de realce corticomedular notablemente menor que el de células claras. Si el tumor es grande, también puede mostrar degeneración quística, necrosis, calcificaciones, cambios hemorrágicos y, excepcionalmente, grasa macroscópica por macrófagos cargados de colesterol. Normalmente tiene una señal T2 hipointensa. La presentación bilateral y multifocal es más frecuenteque en el resto de los subtipos, especialmente en las formas hereditarias.

EL carcinoma papilar presenta poco realce tras la administración de contraste (ROI 47 UH sin ccontraste vs 75 UH con contraste). Diferente al CCR de células claras.
3). CCR CROMÓFOBO:
Suele tener un realce homogéneo de intensidad moderada, y puede presentar una cicatriz central, hallazgo clásicamente asociado al oncocitoma (comparte características ontogénicas con este tumor). T2 hipointensa, como el papilar y los angiomiolipomas pobres en grasa.
4). OTROS CCR:
CCR quístico multilocular, de componente quístico con múltiples septos de tamaño variable que pueden calcificar. Carcinoma renal de Túbulos Colectores, poco frecuente (<1%) muy agresivo por su patrón infilrativo, cuando es pequeño tiene el epicentro en la medular renal. CCR medular renal, asociado a jóvenes con anemia falciforme, muy maligno, lesión infiltrativa heterogénea medular renal, típicamente asociado a caliectasia y con rápida tendencia a las metástasis linfohematógenas. Carcinoma renal tubular mucinoso y de células fusiformes, reciente inclusión como subtipo de CCR, no presenta una característica radiológica específica diferencial.
EXTENSIÓN:
Usaremos la clasificación TNM.
Un pacicente con diagnóstico de CCR necesita un estudio de extensión. La identificación de invasión de la grasa perinéfrica y fascia renal, la extensión a vena renal o vena cava, adenopatías regionales, invaisón de órganos adyacentes o enidencia de métastasis a distancia suponen hallazgos claves para la correcta estadificación del proceso. En pacientes con tumores pequeños inferiores a 3 cm, valdría con hacer una radiografía de tórax.
Especial mención suponen las localizaciones más frecuentes de métastasis del CCR: Pulmones, Mediastino, Hueso e Hígado. Menos frecuentes son en el riñón contralateral, la glándula adrenal, páncreas, mesenterio y pared abdominal.
La presencia de un tumor sincrónico en el riñón contralateral es baja (<2%), así como la prevalencia de bilateralidad (<2%) y la multicentricidad (<25%).
Hay que tener en cuenta otros factores como la relación con determinados síndromes hereditarios, el Von Hippel Lindau con el CCR de células claras es el más frecuente y conocido, y también señalar que los pacientes en fracaso renal pueden desarrolar tumores en el seno de la enfermedad quística adquirida por diálisis, por lo que deben vigilarse.
Existen otros tumores tanto benignos como malingos que afectan al tumor, destacamos:
- METÁSTASIS: Estadisticamente es el tumor maligno que más afecta al riñón. El riñón es el 5º lugar de afectación por metástasis hematógenas de pulmón, mama, gastrointestinal y melanoma, que son los que más lo afectan. En CT veremos que las metástasis son típicamente pequeñas, multifocales, bilaterales y exhiben un patrón de crecimiento infiltrante. La captación de contraste es menor que el resto del parénquima renal, así que pueden ser rápidamente identificadas. Raramente, pueden manifestarse como una lesión exofítica indistinguible de un CCR, para lo que la biopsia será una gran herramienta de diferenciación.
- OTROS: Carcinoma de células transicionales, Oncocitoma, Angiomiolipoma, Linfoma.
Bibliografía:
http://pubs.rsna.org/doi/pdf/10.1148/radiographics.21.suppl_1.g01oc18s237
http://pubs.rsna.org/doi/pdf/10.1148/rg.266065010




Deja un comentario